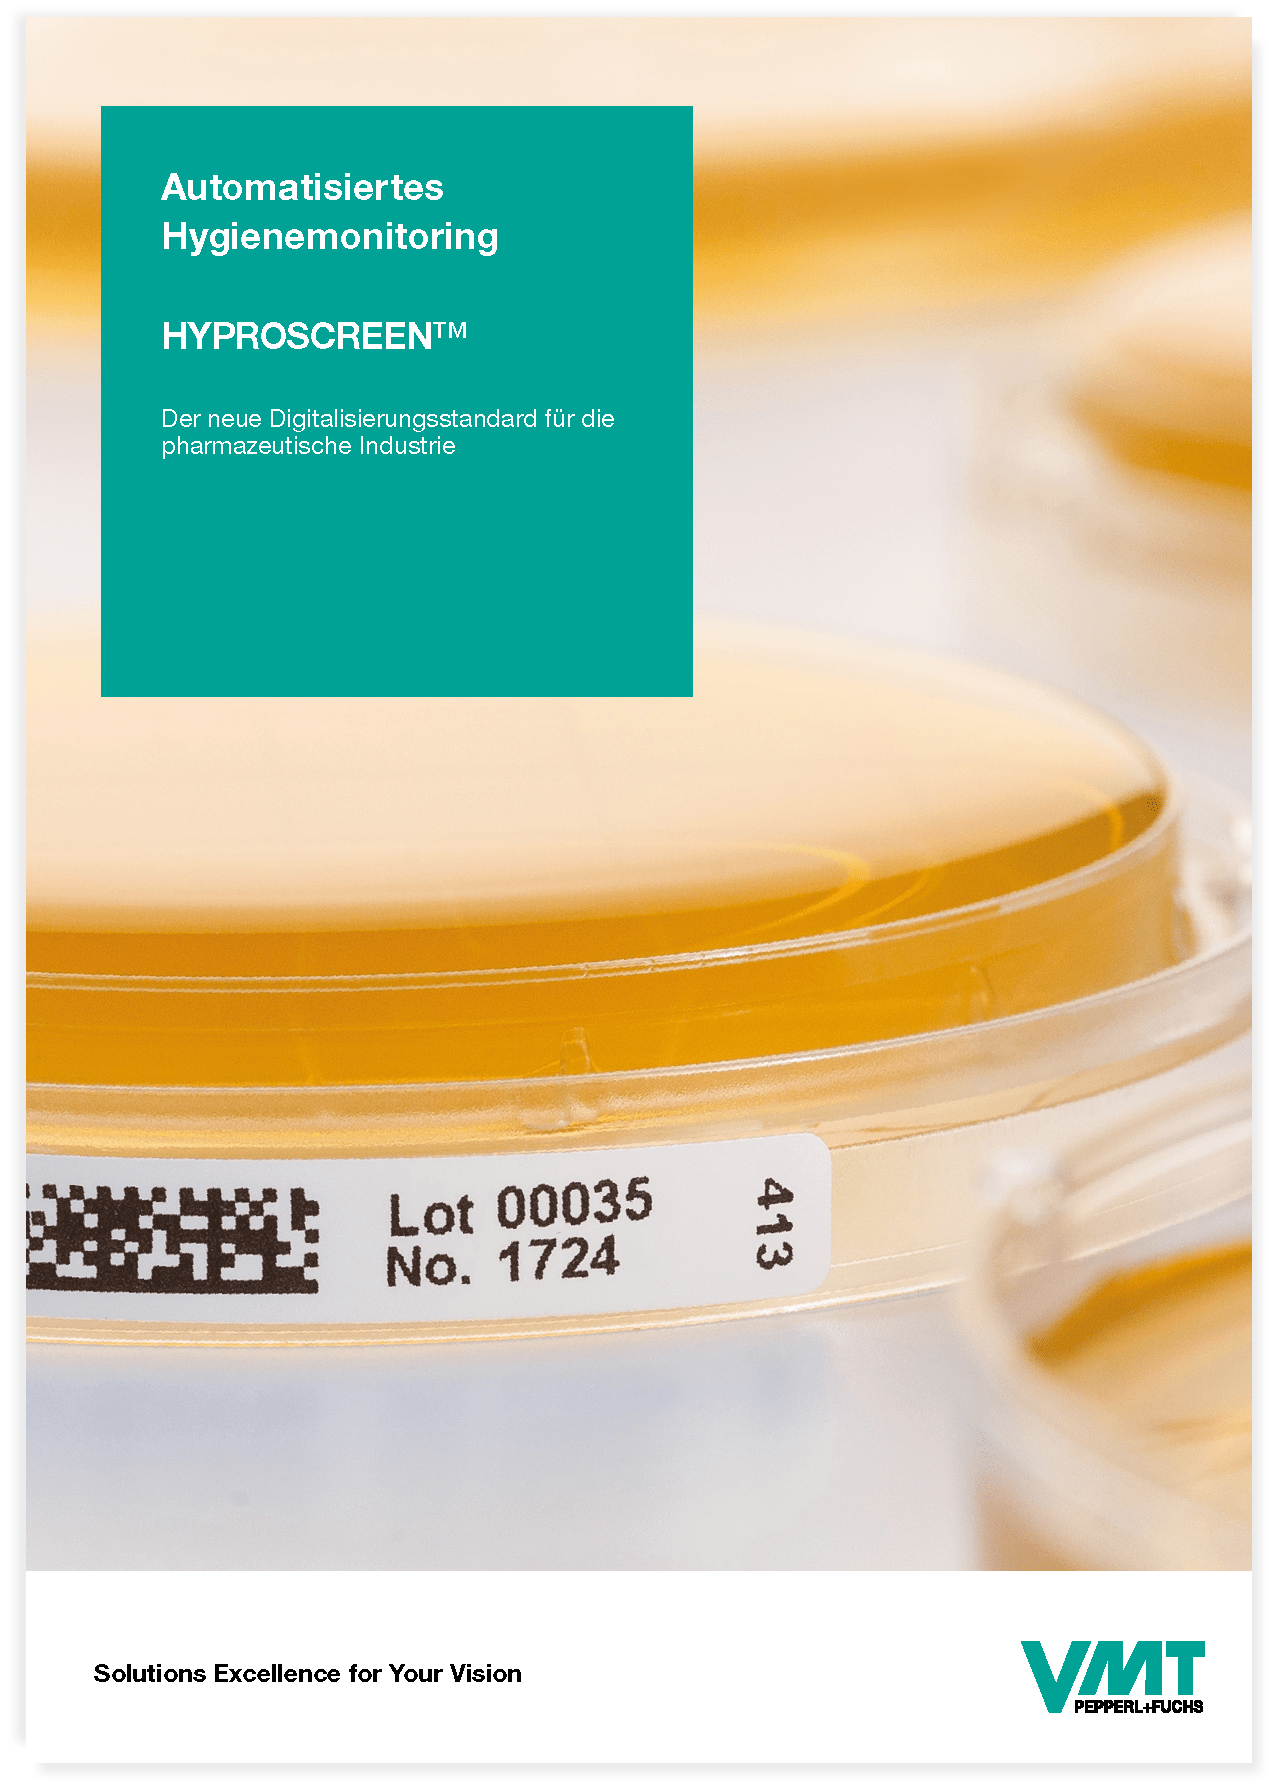
Bildverarbeitung und Lasermesstechnik - VMT Bildverarbeitungssysteme GmbH

Downloads für alle Industriesparten
 VMT Vision-Lösungen für die Logistik
VMT Vision-Lösungen für die Logistik
Depalettieren mit VMT DeStack
Bin-Picking mit VMT PickFinder
Pressteil-Handling mit VMT FrameSense
Automatische Korrektur von Roboterbahnen mit VMT BK
Download
 3D Roboterführung durch intelligente Behälterprüfung
3D Roboterführung durch intelligente Behälterprüfung
Einstapeln von Pressteilen mit VMT FrameSense
Machine Vision
Abgestimmt auf Ihren Prozess
Neue Dimensionen der 3D Bildverarbeitung
Punktewolkenbasierte 3D-Lagebestimmung
Ohne Unterbrechung zuverlässig & präzise
VMT PickFinder 3D
Vollständig modular und hochpräzise
Automatisierte Fügeprozesse mit VMT Sense&Place
Kleberaupenkontrolle perfekt abgestimmt
VMT SpinTop G2
TCP Kontrolle, Korrektur und Vermessung „out-of-the-box"
VMT ToolBox 3D
Platzsparende Stereo-Bildverarbeitung vielseitig, präzise und netzwerkfähig
VMT TwinCam
Industrielle Bildverarbeitung und Lasermesstechnik
Für alle Industriesparten
Downloads für den Bereich LifeScience
Kompetente Bildverarbeitungslösungen für den Bereich LifeScience
Kompetente Bildverarbeitungslösungen für den Bereich LifeScience
VMT MultiCount: Automatische Bilanzierung von Vials, Ampullen, Spritzen und Karpulen
Download
Automatisiertes Hygiene Monitoring - HYPROSCREENTM
Der neue Digitalisierungsstandard für die pharmazeutische Industrie Solutions
Downloads Zertifikate
![]() DIN EN ISO 9001:2015 DE
DIN EN ISO 9001:2015 DE
![]() DIN EN ISO 9001:2015 ENG
DIN EN ISO 9001:2015 ENG
![]() DIN EN ISO 14001:2015 DE
DIN EN ISO 14001:2015 DE
![]() DIN EN ISO 14001:2015 ENG
DIN EN ISO 14001:2015 ENG
Downloads für den Servicebereich
Downloads zu unseren AGBs und Datenschutz
![]() Eigentumsvorbehaltsbedingungen
Eigentumsvorbehaltsbedingungen
![]() Allgemeine Datenschutzhinweise
Allgemeine Datenschutzhinweise